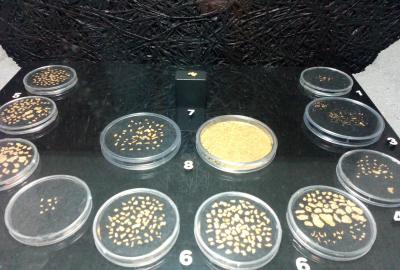

Jak jsme si narýžovali
24.5.2024 se 9.C vypravila do Horažďovic rýžovat zlato. A přišla i Libuška.

Nejprve jsme navštívili horažďovické muzeum, kde nás pan Aleš Červený provedl sbírkami minerálů s podtitulem MYSLÍ A KLADIVEM – Minerály, hornictví, zlato a perly horního Pootaví, které z naprosté většiny i sám pořídil. Byli jsme překvapeni, jaké krásné krystaly se nachází v našem okolí, poučeni o chovu perlorodek na Otavě, rýžování zlata a těžbě minerálů v našem regionu.
Pak jsme se vypravili k řece, kouknout, jestli nám Keltové něco nenechali. Jelikož byl silný proud, nemohli jsme rýžovat pod Práchní, kde je podle našeho průvodce zlata nejvíc, ale zkusili jsme štěstí u sportovního areálu Na Lipkách. A vyplatilo se. Každý, kdo se nebál studené vody, si odnesl trochu zlatého prachu. Na naše úspěchy se přišla podívat i paní učitelka Junková